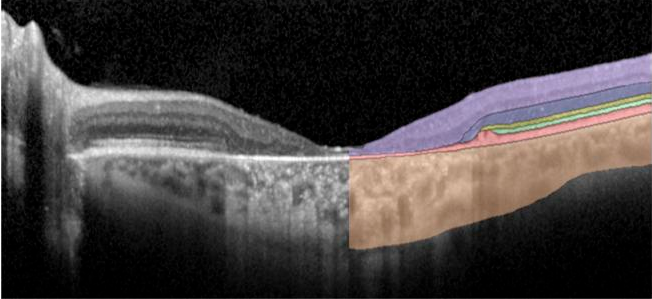
OCT image with colored segmented retinal layers.

May 10th, 2022 | VIRTUAL | 10AM – 5PM ET
This virtual NEI, FDA, and ONC hosted workshop will focus on delineating the state of the science and improving interoperability among ocular imaging modalities and devices to improve biomedical research and patient care. This meeting will consist of a day of discussion that will identify the gaps in knowledge, barriers to progress, and potential strategies for overcoming them in the context of addressing the goal of Promoting the Adoption of Ocular Imaging Standards. This will be an open workshop to the general public, and it is anticipated that researchers from academia, industry, non-profits, other government agencies, patients and care partners will attend. The discussion will be disseminated to the vision community in the form of a published white paper.
Spectral-domain optical coherence tomography uses light to image layers of the retina. Image Courtesy of: Brian P. Brooks, M.D., Ph.D. and Brett G. Jeffrey, Ph.D.
Agenda
10:00 a.m. - 11:25 a.m. -- Session 1
Where Are We Now and Where Do We Want to Be?
- Opening Remarks – Michael F. Chiang (National Eye Institute)
- Experience in Radiology – Charles Kahn (Radiological Society of North America & University of Pennsylvania)
- Imaging Standards: Why Are They Important? - Krishna Juluru (National Institute of Biomedical Imaging and Bioengineering)
- Ocular Imaging in the Eye Clinic – Michael V. Boland (Massachusetts Eye and Ear & Harvard Medical School)
- Ocular Imaging Technologies in Research – Aaron Lee (University of Washington School of Medicine)
- Ocular Imaging in Sponsored Biomedical Studies – Daniela Ferrara (Genentech & Tufts University)
11:25 a.m. – 12:10 p.m. -- Session 2
What do we need to reach the “Vision for the Future”?
Moderator - Amberlynn Reed (National Eye Institute)
- FDA Device Standard Recommendations – Elvin Ng (U.S. Food and Drug Administration)
- ONC Interoperability with EHRs – Andrew Northup (Office of National Coordinator for Health Information Technology)
- US Core Data for Interoperability (UCSDI) – Albert Taylor (Office of National Coordinator for Health Information Technology)
12:10 p.m. - 12:40 p.m. -- BREAK
12:40 p.m. - 2:10 p.m. -- Session 3
Panel Discussion: How to address barriers to adoption of DICOM
Moderator – Kerry Goetz (National Eye Institute)
- Charles Reisman (Heidelberg Engineering)
- Niranchana Manivannan (Carl Zeiss Meditec, Inc.)
- Bradley Yates (Optos)
- Joel Schuman (NYU Langone Health)
- Emily Y. Chew (National Eye Institute)
- Elizabeth Murphy (National Eye Institute)
- LTC Marcus Colyer (Madigan Army Medical Center)
- CPT Boonkit Purt (Walter Reed National Military Medical Center)
- Kaushal Solanki (Eyenuk, Inc.)
- Michael D. Abramoff (Digital Diagnostics)
- Naama Haamel (Google Health)
- Raymond Iezzi (Mayo Clinic Platform)
2:10 p.m. - 3:10 p.m. -- Session 4
Panel Discussion: How can meaningful adoption be evaluated and what else is needed (beyond DICOM)?
Moderator – Afrouz Anderson (National Institute of Biomedical Imaging and Bioengineering)
Presenters:
- Thomas Keane (Office of National Coordinator for Health Information Technology)
- Tieuvi Nguyen (U.S. Food and Drug Administration)
- Jimmy Le (National Eye Institute)
Panelists:
- Linda Wedemeyer (Veterans Health Administration)
- Amitha Domalpally (Wisconsin Reading Center)
- Durga Borkar (Duke University & Verana Health)
- Krishna Juluru (National Institute of Biomedical Imaging and Bioengineering)
- Aaron Lee (University of Washington School of Medicine)
3:10 p.m. - 3:40 p.m. -- BREAK
3:40 p.m. - 5:00 p.m. -- Session 5
Panel Discussion: Approaches to Address the Challenges for Imaging Standardization to Improve the Eco-System of Ocular Imaging
Moderator – Thomas Keane (Office of National Coordinator for Health Information Technology)
- Flora Lum (American Academy of Ophthalmology)
- SriniVas R. Sadda (Doheny Eye Institute & Association for Research in Vision and Ophthalmology)
- Michael F. Chiang (National Eye Institute)
- Micky Tripathi (Office of National Coordinator for Health Information Technology)
- Malvina Eydelman (U.S. Food and Drug Administration)
Closing Remarks – Michael F. Chiang (National Eye Institute)
Closed captioning will be provided for this event. If you need additional accommodations to participate in this workshop, please contact the Office of Data Science and Health Informatics staff at NEIODSHI@nei.nih.gov at least 48 hours prior to the event.
Presenters
Michael Abramoff, M.D., Ph.D.
Founder and Executive Chairman
Digital Diagnostics

Dr. Abramoff is a fellowship‐trained retina specialist, computer scientist and entrepreneur. He is Founder and Executive Chairman of Digital Diagnostics, the first company ever to receive FDA clearance for an autonomous AI diagnostic system. To transform the quality, accessibility, and affordability of global healthcare through the automation of medical diagnosis and treatment. Dr. Abramoff (FARVO) is the Robert C. Watzke, M.D. Professor of Ophthalmology and Visual Sciences at the University of Iowa, with a joint appointment in the College of Engineering. He is the Founder and Executive Chairman of Digital Diagnostics, the Autonomous AI diagnostics company that was the first in any field of medicine to get FDA clearance for an autonomous AI.
Afrouz Anderson, Ph.D.
Program Director
Division of Applied Science and Technology (Bioimaging)
Optical Imaging and Spectroscopy
National Institute of Biomedical Imaging and Bioengineering, NIH

Dr. Anderson received her Ph.D. degree in biomedical engineering from the University of California, Davis. Her research mainly focused on translational biophotonics and utilization of multi‐modality imaging in clinical populations. As a Program Director at the National Institute of Biomedical Imaging and Bioengineering she oversees the optical imaging and spectroscopy portfolio.
Michael V. Boland, M.D., Ph.D.
Associate Professor, Ophthalmology
Harvard Medical School Medical Director of Practice Innovation
Massachusetts Eye and Ear

Dr. Boland is the Medical Director of Practice Innovation for Ophthalmology at Massachusetts Eye and Ear and a member of the faculty at Harvard Medical School. His research and administrative work has focused on the integration of clinical information systems and on improving the diagnosis and management of glaucoma by analyzing the results of in‐office testing. In addition to his work on medical information technology at his home institutions, he has served on the Medical Information Technology Committee of the American Academy of Ophthalmology and has worked with DICOM Working Group 9 on standards for ophthalmology testing devices, leading the development of the DICOM standard for automated perimetry.
Durga Borkar, M.D.
Assistant Professor of Ophthalmology
Duke University

Dr. Borkar is a board‐certified, fellowship‐trained adult vitreoretinal surgeon. Her practice includes injection and laser‐based treatment of retinal disease in the clinic, as well as complex surgical cases in the operating room. She specializes in diabetic retinopathy, macular degeneration, retinal vascular occlusion, macular edema, macular holes, epiretinal membranes, vitreomacular traction, secondary intraocular lens placement, and complex retinal detachments, among others. Dr. Borkar’s academic interests include clinical outcomes research utilizing large administrative datasets, such as insurance claims data.
Emily Y. Chew, M.D.
Director
Division of Epidemiology and Clinical Applications
National Eye Institute, NIH

Dr. Chew is the Director of the Division of Epidemiology and Clinical Applications at the National Eye Institute (NEI), National Institutes of Health. She is an ophthalmologist and medical retina specialist who also heads the Clinical Trials Branch at NEI. She chairs clinical trials for age‐related macular degeneration (AMD), diabetic retinopathy, and other rare retinal diseases. She also collaborates with colleagues at the National Library of Medicine utilizing both artificial intelligence/deep learning on the detection and progression of AMD and images from clinical trials and other epidemiologic studies. She focuses on outcome measurements for clinical trials. Dr. Chew is an active member of the Collaborative Community on Ophthalmic Imaging group formed to identify obstacles, best practices, strategies, and standards to accelerate innovation in ophthalmic imaging that improves patient outcomes.
Michael F. Chiang, M.D.
Director
National Eye Institute, NIH

Dr. Chiang joined the National Eye Institute as Director in November 2020 with a background shaped by the intersection of patient care and information technology. His clinical practice focuses on pediatric ophthalmology and strabismus, and he is board‐certified in clinical informatics. His research develops and applies biomedical informatics methods to areas of clinical ophthalmology.
LTC Marcus Colyer, M.D.
Vitreoretinal Surgeon
Madigan Army Medical Center, U.S. Army

Dr. Colyer is an Army retina specialist and Consultant to the Surgeon General for Ophthalmology. He received an M.D. degree from Penn State University and subsequently completed residency at Walter Reed in 2008. He completed a surgical retina fellowship at Georgetown University/Retina Group of Washington. Dr. Colyer has authored or co‐authored more than 50 manuscripts related to ocular trauma and visual dysfunction following combat injuries. He has served as a residency program director and department chair. He leads the U.S. military’s initiative to integrate ophthalmic imaging and data with MHS GENESIS—the military’s implementation of Cerner—and has specific interests related to implementing scalable solutions to improve device cybersecurity and reliable data connectivity in ophthalmic equipment.
Amitha Domalpally, M.D., Ph.D.
Research Director
Wisconsin Reading Center

Dr. Domalpally is the Research Director of the Wisconsin Reading Center, one of the world’s leading diagnostic imaging centers for both patient diagnosis and clinical trials. Her work investigates clinical trial imaging endpoints for retinal diseases, with a focus on employing new imaging techniques to understand the natural history and prognostic markers of diseases such as age‐related macular degeneration (AMD), diabetic retinopathy, and many others. In collaboration with National Eye Institute and other researchers around the nation, Dr. Domalpally led the imaging endpoints for the Age‐Related Eye Disease Study 2(AREDS2), an influential study investigating the role of supplements in AREDS formulation for
age‐related macular degeneration (AMD) treatment.
Malvina Eydelman, M.D.
Office Director
Office of Product and Evaluation
Center for Devices and Radiological Health
U.S. Food & Drug Administration

Dr. Eydelman is the Director of the Office of Ophthalmic, Anesthesia, Respiratory, ENT and Dental Devices at the U.S. Food & Drug Administration. She leads development, implementation, execution, and management of the premarket, postmarket, compliance, and quality programs. Dr. Eydelman guided development of more than 50 international and national standards, oversaw development of numerous regulations and guidance, and has been instrumental in expediting development of novel endpoints for clinical trials of pioneering technologies. She received graduate degrees from Harvard Medical School and the Massachusetts Institute of Technology.
Daniela Ferrara, M.D., M.S., Ph.D.
Principal Medical Director
Genentech, Inc.

Dr. Ferrara is an ophthalmologist and retina specialist with 25 years of clinical practice and clinical research experience. She is Assistant Professor of Ophthalmology at Tufts University School of Medicine, where she leads exploratory research on new imaging technologies for dystrophic and degenerative diseases of the retina and reading center activities focused on new imaging biomarkers. She currently serves as Principal Medical Director for Genentech/Roche leading the ophthalmology branch of the Personalized Healthcare Program, which aims to use digital innovation, advanced analytics, and artificial intelligence to improve patient outcomes at the point of care or in clinical trials for vision‐threatening diseases.
Kerry Goetz, M.S.
Associate Director
Office of Data Science and Health Informatics
National Eye Institute, NIH

Ms. Goetz is the Associate Director for the National Eye Institute’s (NEI) Office of Data Science and Health Informatics. In this capacity she is responsible for advancing data management and sharing strategies to make NEI data FAIR (Fully AI‐Ready and Findable, Accessible, Interoperable, and Reusable). For more than a decade, Ms. Goetz has been leading the eyeGENE Program, a controlled access resource with data, samples, and a patient registry for rare eye conditions. She has implemented sharing of several other clinical trial datasets through NEI BRICS, part of the NEI Data Commons. She has also been entrenched in standards development through the National Institutes of Health’s Common Data Elements (CDE) Task Force since 2011 and has worked closely with LOINC to create and review ophthalmology codes.
Naama Hammel, M.D.
Clinical Research Scientist
Google Health

Dr. Hammel is a Clinical Research Scientist at Google Health. In this role she focuses on developing machine learning models for the detection of ocular and systemic diseases from medical images. She is an ophthalmologist with a subspecialty in glaucoma. She completed her medical and ophthalmology training at Tel‐Aviv University; her glaucoma fellowship at the Shiley Eye Institute, University of California, San Diego; and her ophthalmic informatics fellowship at the University of California, Davis Eye Center.
Syed Haqqani, M.S.
Health Science Policy Analyst
Office of Data Science and Health Informatics
National Eye Institute, NIH

Mr. Haqqani is a Health Science Policy Analyst at the National Eye Institute (NEI)’s Office of Data Science and Health Informatics. In this capacity, he is responsible for implementing data standards and data science principles to make NEI data FAIR (Findable, Accessible, Interoperable, and Reusable). His interests include analyzing ocular images, creating data visualizations, promoting tools for data management and sharing, and data mining.
Raymond Iezzi, M.D.
Chair
Ophthalmology Platform
Mayo Clinic Platform

Dr. Iezzi conducts preclinical and clinical translational trials in several ophthalmology‐related areas. His clinical interests include retinal degenerative diseases as well as all aspects of vitreoretinal surgery, with a special interest in complex retinal detachment repair associated with diabetes, trauma and proliferative vitreoretinopathy.
Krishna Juluru, M.D.
Presidential Innovation Fellow
National Institute of Biomedical Imaging and Bioengineering, NIH

Dr. Juluru helps to informatics initiatives at National Institute of Biomedical Imaging and Bioengineering. Prior to his current role, he led informatics programs at large academic medical centers, including Memorial Sloan Kettering Cancer Center and Weill Cornell Medicine. He serves on national professional society Informatics committees and is Associate Editor for Informatics of the journal Radiographics. The themes of his more recent publications have been on integrating artificial intelligence solutions into clinical workflow. Dr. Juluru earned a B.S. degree in applied physics from Yale University and an M.D. from Johns Hopkins University and completed fellowships in magnetic resonance imaging and imaging informatics.
Charles Kahn, Jr., M.D., M.S.
Professor and Vice Chair, Radiology
University of Pennsylvania

Dr. Kahn is Professor and Vice Chair of Radiology at the University of Pennsylvania. He served two terms as User Co‐Chair of the DICOM Standards Committee and has developed systems for structured reporting and decision support. He currently serves as Editor of the journal Radiology: Artificial Intelligence.
Thomas Keane, M.D.
Clinical Officer
Office of the National Coordinator for Health IT

Dr. Keane is Senior Advisor to the National Coordinator for Health IT. He has been in practice as a radiologist for more than decade, and before entering medical school he worked as a professional software developer for 5 years.
Jimmy Le, Sc.D., M.A.
Program Director, Collaborative Clinical Research
National Eye Institute, NIH

Dr. Le is Program Director for Collaborative Clinical Research at the National Eye Institute (NEI). He is responsible for advancing and administering a large program of federally supported complex, multi‐site epidemiologic studies and clinical trials that address eye and vision conditions. He also represents the NEI on trans‐NIH committees and initiatives, including the Obesity Research Task Force; Transformative Health Disparities Working Group; Rural Health Working Group; and Social, Behavioral, and Economic Health Impacts of COVID‐19. Dr. Le received his undergraduate degree from the University of California, Berkeley; an M.A. degree in international affairs from the Institute of Political Studies (Sciences Po) in Paris; and an Sc.D. degree in epidemiology from the Johns Hopkins University.
Aaron Y. Lee, M.D., MSCi
Associate Professor and Vitreoretinal Surgeon
Department of Ophthalmology
University of Washington

Dr. Lee is an Associate Professor and Vitreoretinal Surgeon at the University of Washington, Department of Ophthalmology, and the recent recipient of the C. Dan and Irene Hunter Endowed Professorship. He completed his undergraduate degree at Harvard University and his medical training at Washington University in St. Louis. He chairs the American Academy of Ophthalmology Information Technology Steering Committee. He currently serves as an Associate Editor for both Translational Vision Science and Technology and Ophthalmology Science, and on the Editorial Board for the American Journal of Ophthalmology and Nature Scientific Reports. He has published more than 100 peer‐reviewed manuscripts and is known as a leader in the field of artificial intelligence and ophthalmology. Dr. Lee’s research is focused on the translation of novel computation techniques in machine learning to uncover new disease associations and mechanisms from routine clinical data including electronic health records and imaging.
Flora Lum, M.D.
Vice President, Quality and Data Science
American Academy of Ophthalmology

Dr. Lum is the Vice President for Quality and Data Science for the American Academy of Ophthalmology. She has overseen the Academy IRIS® Registry (Intelligent Research in Sight) since its inception, and she supervised the registry’s data management, reporting, and analytic activities. She has also overseen the Academy information technology standard development activities for terminology, imaging, and interoperability, including 10 DICOM standards that cover the majority of ophthalmic digital imaging modalities, as well as expanded SNOMED terminology to cover a majority of ophthalmic terms, and 9 Integrating the Healthcare Enterprise workflow and clinical document architecture standards
for information exchange.
Niranchana Manivannan, Ph.D.
Head, Algorithm Development and Clinical Research
Carl Zeiss Meditec, Inc.

Dr. Manivannan has a Ph.D. degree in electrical and computer engineering. She has a background in radiology and in developing AI solutions for ophthalmic diagnostics. She is currently the Head of Algorithms Development and Clinical Research in Ophthalmic Diagnostics Business Segment at ZEISS.
Elizabeth Murphy, Ph.D.
Chief, Clinical Informatics Section
National Eye Institute, NIH

Dr. Murphy has been with the National Eye Institute (NEI) intramural clinical program since 2000, after completing her bachelor’s degree in biochemistry at the University of California, Berkeley and Ph.D. degree in biophysics at Johns Hopkins University. She brought the NEI’s electronic health record (EHR) system online in 2002, and has been working since then to integrate the ophthalmic imaging equipment and create a robust clinical and research architecture. She is currently seeking to simplify clinical access to multi‐modal imaging and reducing barriers to research with images within the NEI clinical program.
Elvin Ng
Assistant Director
Retinal and Diagnostics Devices Team
Center for Devices and Radiological Health
U.S. Food & Drug Administration

Mr. Ng is Assistant Director for the Retinal and Diagnostics Team. As part of the Ophthalmic Devices Division in the Center for Devices and Radiological Health at the U.S. Food & Drug Administration, his team is responsible for the total product lifecycle review for ophthalmic medical devices, participation in the development of guidance documents and consensus standards, and development and interpretation of regulations and policies. The Retinal and Diagnostics team reviews devices that include artificial intelligence/deep learning diagnostic software, vision restoration bioelectric implants, and head‐mounted display therapeutics.
Tieuvi Nguyen, Ph.D.
Director, Division of Ophthalmic Devices
Center for Devices and Radiological Health
U.S. Food & Drug Administration

Dr. Nguyen currently serves as Director of the Division of Ophthalmic Devices in the Center for Devices and Radiological Health. In this role, she oversees various scientific and regulatory policies related to the premarket approval, postmarket performance and surveillance, and compliance and enforcement of ophthalmic devices. Prior to joining the U.S. Food & Drug Administration, Dr. Nguyen held numerous positions in the pharmaceutical and finance industries.
Andrew Northup
Public Health Analyst
Digital Interoperability and Health IT Standards
Office of the National Coordinator for Health Information Technology

Mr. Northup is a Public Health Analyst in the Terminology, Content, and Delivery Branch of the Standards Division, within the Office of the National Coordinator for Health Information Technology’s (ONC) Office of Technology (OTECH). He leads ONC’s work on laboratory interoperability, and serves as a subject matter expert for medical imaging, mobile health, and medical device IT interoperability standards. Prior to ONC, Mr. Northup held roles at the American Petroleum Institute and the Medical Imaging and Technology Alliance. He worked in standards development for quality management, measurement, patient and worker safety, and health IT, and was honored as an IEC Young Professional and an ANSI Next Generation awardee. He began his healthcare career in community health, working in both urban and rural health centers in Washington, DC, and his native Iowa.
Boonkit Purt, M.D.
Assistant Professor of Surgery
Walter Reed National Military Medical Center
U.S. Army

Dr. Purt currently serves as the technical lead on the Department of Defense’s ophthalmic imaging effort. He is a member of the faculty for the Walter Reed/Fort Belvoir ophthalmology residency program. He has combined his experience in software engineering and ophthalmology to bridge the gap between the clinical and technical worlds, often interfacing directly with engineers to improve ophthalmic imaging equipment to better meet the needs of doctors, patients, and the Department of Defense (DoD). Over the past 7 years, he has worked with virtually all major device manufacturers to improve compatibility between systems, including storage and archival of DoD ophthalmic imaging studies and the deployment of a single Ophthalmic PACS system across the Military Health System.
Amberlynn Reed, M.P.H.
Health Program Specialist
Office of Data Science and Health Informatics
Office of Regenerative Medicine
National Eye Institute, NIH

Ms. Reed is a Health Program Specialist for the National Eye Institute (NEI) who is currently splitting her time between the Office of Regenerative Medicine and the Office of Data Science and Health Informatics. Before joining, Ms. Reed served in the U.S. Air Force as a Public Health Technician. She earned an M.P.H. from The George Washington University and dual B.S. degrees in social psychology and public health from American Military University.
Charles Reisman, M.S.
Scientific Director, Product Management
Heidelberg Engineering

Mr. Reisman holds the post of Scientific Director and also heads up the global Clinical Trials function at Heidelberg Engineering. He has developed leading commercial spectral domain and swept source optical coherence tomography (OCT) imaging systems and features.
SriniVas R. Sadda, M.D., FARVO
Director, Artificial Intelligence and Imaging Research
Doheny Eye Institute
University of California, Los Angeles

Dr. Sadda is the Director of Artificial Intelligence and Imaging Research at the Doheny Eye Institute, and Professor of Ophthalmology at the University of California, Los Angeles Geffen School of Medicine. He received his M.D. from Johns Hopkins University, where he also completed ophthalmology residency and neuro‐ophthalmology and medical retina fellowships (Wilmer Eye Institute). He served as Assistant Professor of Ophthalmology at Johns Hopkins before being recruited to Doheny. Dr. Sadda’s major research interests include retinal image analysis, advanced retinal imaging technologies, and clinical trial endpoint design.
Joel S. Schuman, M.D., FACS
Elaine Langone Professor and Vice Chair for Research, Ophthalmology
Professor of Neuroscience and Physiology
NYU Langone Health

Dr. Schuman is the Elaine Langone Professor and Vice Chair for Research in the Department of Ophthalmology and Professor of Neuroscience and Physiology at NYU Langone Health, NYU Grossman School of Medicine, Professor of Biomedical Engineering and Electrical and Computer Engineering at NYU Tandon School of Engineering, and Professor of Neural Science in the Center for Neural Science at NYU College of Arts and Sciences. Dr. Schuman and his colleagues were first to identify a molecular marker for human glaucoma, published in Nature Medicine in 2001. Continuously funded by the National Eye Institute as a principal investigator since 1995, he is an inventor of optical coherence tomography, used world‐wide for ocular diagnostics. Dr. Schuman has published more than 450 peer‐reviewed scientific journal articles.
Kaushal Solanki, Ph.D.
Chief Executive Officer and Founder
Eyenuk, Inc.

Dr. Solanki is the Founder and CEO of Eyenuk, Inc. He pioneered the development, prospective clinical validation, regulatory process, and commercialization of the EyeArt® system, Eyenuk’s flagship autonomous AI product for autonomous detection of diabetic retinopathy. This system was developed with funding from NIH and validated by the U.K. National Health Service, and has received global regulatory approvals including clearance by the U.S. Food & Drug Administration, CE Marking, and a Health Canada license. Prior to founding Eyenuk, Kaushal was a lead research scientist at Mayachitra, Inc., where he led cutting‐edge projects on image analysis from concept to commercialization. He holds a Ph.D. degree in electrical and computer engineering from the University of California, Santa Barbara. His journal publications have been cited more than 1,500 times, and he holds several issued and pending patents.
Albert Taylor, M.D.
Medical Informatics Officer
Office of the National Coordinator for Health Information Technology

Dr. Taylor is a Medical Informatics Officer at ONC, responsible for promoting standards‐based interoperability, clinical quality improvement and clinical decision support in Health IT. He practiced obstetrics and gynecology in the Army for 20 years and served as Deputy CMIO at Womack Army Medical Center in Fort Bragg before joining ONC in 2015.
Micky Tripathi, Ph.D., M.P.P.
National Coordinator for Health Information Technology
Office of the National Coordinator for Health IT

Dr. Tripathi is the National Coordinator for Health Information Technology at the U.S. Department of Health and Human Services, where he leads the formulation of the federal health IT strategy and coordinates federal health IT policies, standards, programs, and investments. Dr. Tripathi has more than 20 years of experience across the health IT landscape.
Linda Wedemeyer, M.D., R.N., M.S.
Physician Informatician, Health Informatics/Knowledge Based Systems
Veterans Health Administration

Dr. Wedemeyer is an ophthalmologist and now Physician Informatician at the U.S. Department of Veterans Affairs (VA0 in the Clinical Decision Support (CDS) group working on standards‐based creation of knowledge artifacts for CDS. She did volunteer work for AAO for many years helping to create eye care DICOM standards, IHE Profiles, and CDAs. At the VA she currently leads the eye care sub‐ group in planning for an enterprise‐wide vendor neutral image archive for specialties.
Bradley Yates
Vice President, Product Management
Optos

Mr. Yates has served as Vice President for Product Management and an Executive Team member for Optos, a Division of Nikon, for the last 9 years. Previously, he was an Ophthalmic Photographer, working in Ophthalmic Imaging in Texas, and introduced electronic health records into Parkland Hospital, before transitioning to the imaging vendor side. Mr. Yates graduated with a degree in scientific imaging and color technology from Brooks Institute.